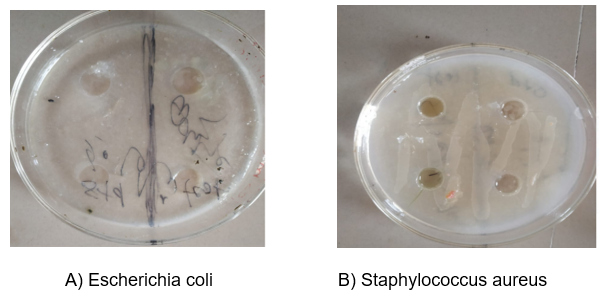

We use cookies to ensure our website works properly and to personalise your experience. Cookies policy

We use cookies to ensure our website works properly and to personalise your experience. Cookies policy
Siddhi's Institute of Pharmacy, Nandgaon.
Brahmi is a well-known medicinal herb with therapeutic and antimicrobial properties. Brahmi was extracted using the reflux method with methanol as the solvent, known for efficiently extracting bioactive phytochemicals. The obtained extract was incorporated into granules using the wet granulation method. Other excipients like lactose (diluent), acacia (binder), talc (glidant), and magnesium stearate (lubricant) were used in varied concentrations across three different batches. Neem powder was also included for its synergistic antimicrobial effect in some batches. The formulated granules were evaluated for various physicochemical properties, including flow property, particle size (passed through sieve #20), friability, color, odor, and taste. The antimicrobial activity of each batch was tested against Escherichia coli and Staphylococcus aureus using the agar diffusion method. The results were compared with a standard drug, Norfloxacin. The formulation with both Brahmi and Neem enhanced antimicrobial activity, indicating a synergistic effect.
The exposure and rapid spread of antimicrobial resistance (AMR) pose one of the greatest challenges to global public health in the twenty-first century. Decades of extensive antibiotic use—both appropriate and inappropriate—have applied intense evolutionary pressure on pathogenic bacteria, leading to the selection and proliferation of resistant strains. The World Health Organization (WHO) has identified AMR as a major threat to progress in modern medicine, the effective treatment of infections, undermining surgical procedures, and increasing healthcare costs. In response, researchers worldwide are seeking new antimicrobial agents, novel therapeutic strategies, and alternative approaches—among which medicinal plants and herbal formulations have re-emerged as promising reservoirs of bioactive molecules. Herbal medicines have a long history of use in traditional healing systems around the world. In India, Ayurveda and other ancient systems have categorized hundreds of plants with antimicrobial, anti-inflammatory, antioxidant, and immune-modulating activities. Although many ancient texts emphasize the use of whole plant powders, decoctions, and oils, modern pharmaceutical development requires standardized, stable, and patient-friendly dosage forms. This need has driven interest in converting traditional herbal preparations into granules, tablets, capsules, and other advanced delivery systems, thereby combining the benefits of phytotherapy with the rigors of contemporary quality control and formulation science. Among the vast repertoire of Ayurvedic herbs, Bacopa monnieri (commonly known as Brahmi) has attracted considerable attention. Traditionally, Brahmi is celebrated for its nootropic properties—enhancing memory, learning, and cognitive function—and is extensively studied for its neuroprotective, antioxidant, and anti-anxiety effects. The principal active constituents in Brahmi are triterpenoid saponins known as bacosides (primarily bacoside A and B), along with alkaloids (e.g., brahmin), flavonoids, and other polyphenolic compounds. These phytochemicals contribute not only to its cognitive benefits but also to a range of activities including anti-inflammatory, anti-ulcer, hepatoprotective, and indeed antimicrobial effects. The antimicrobial potential of Bacopa monnieri is attributed to its diverse secondary metabolites. Saponins, for instance, can disrupt microbial cell membranes through interaction with sterols, increasing membrane permeability and causing leakage of cellular contents. Flavonoids and polyphenols act as enzyme inhibitors, chelators of metal ions required for microbial growth, and free-radical scavengers that interfere with pathogen survival. Alkaloids often intercalate into microbial DNA or inhibit specific enzymes critical for replication.
Several in vitro studies have demonstrated inhibitory effects of Brahmi extracts against a variety of pathogens:
1) Gram-positive bacteria: Staphylococcus aureus, Bacillus subtilis
2) Gram-negative bacteria: Escherichia coli, Pseudomonas aeruginosa
3) Fungi: Candida albicans, Aspergillus niger
These investigations have employed extraction solvents ranging from water to organic mixtures (ethanol, methanol, diethyl ether, ethyl acetate), revealing that the choice of solvent markedly influences the spectrum and potency of antimicrobial activity. For example, organic extracts often yield higher zones of inhibition in agar diffusion assays, likely reflecting greater solubilization of nonpolar bioactives.
Rationale for Granule Formulation
While many studies report antimicrobial activity in crude extracts, few translate these findings into standardized formulations suitable for preclinical or clinical evaluation. Powders—even when finely milled—can exhibit poor flow, content uniformity challenges, and variable dissolution profiles. Granulation, especially wet granulation, is a time-tested technique in pharmaceutics that improves powder flow, enhances compressibility, and yields granules with more uniform particle size. These granules can be further compressed into tablets or filled into capsules, facilitating precise dosing, ease of administration, and patient compliance.
Key advantages of formulating herbal extracts into granules include:
1. Improved Flow and Compressibility: Granules possess better flow behavior (lower angle of repose) and higher bulk density, reducing manufacturing variability and improving tablet hardness consistency.
2. Controlled Disintegration and Dissolution : By selecting appropriate binders and disintegrants, the release profile of active constituents can be modulated, potentially optimizing bioavailability.
3. Enhanced Stability: Granules packaged in moisture-protective containers exhibit reduced degradation of sensitive phytochemicals compared to loose powders.
4. Standardization: Granule formulations facilitate uniform distribution of active extract throughout the batch, improving reproducibility across production lots.
Objectives and Scope of the Study
The principal aim of this research is to develop and characterize a wet-granulated herbal formulation containing Bacopa monnieri extract with demonstrable antimicrobial activity. To achieve this, the following objectives are delineated:
1. Extraction and Phytochemical Profiling
Shade-dry fresh Brahmi leaves and prepare a coarse powder. Perform solvent extraction (e.g., ethanol) to concentrate bacosides and related metabolites. Conduct qualitative phytochemical tests to confirm presence of saponins, flavonoids, tannins, and alkaloids.
2. Granule Formulation
Optimize a wet granulation procedure, selecting suitable binders (e.g., starch paste, polyvinylpyrrolidone), diluents (lactose, microcrystalline cellulose), and disintegrants (sodium starch glycolate).Evaluate granule characteristics: moisture content, particle size distribution, flow properties (angle of repose, bulk and tapped density, Carr’s index, Hausner ratio).
3. Antimicrobial Efficacy Testing
Prepare standardized granule extracts and perform agar well diffusion assays against representative pathogens (E. coli, S. aureus).Compare zones of inhibition with a reference standard antibiotic (e.g., Norfloxacin).Determine minimum inhibitory concentration (MIC) via broth dilution, if resources permit.
4. Optional Characterization
Assess granular disintegration time, friability, and drug content uniformity. Conduct preliminary stability studies under ambient and accelerated conditions.
5. Data Analysis and Interpretation
Analyze physicochemical and microbiological data using appropriate statistical tools. Discuss implications for herbal dosage form development and potential clinical applications.
Significance of the Study
This research fills a critical gap by bridging empirical antimicrobial findings with practical pharmaceutical formulation of a widely used Ayurvedic herb. By demonstrating that Brahmi extract retains activity when converted into granules—and by establishing robust physicochemical and microbiological evaluation protocols—this work lays the foundation for further scale-up, in vivo pharmacodynamic studies, and eventual clinical translation. Given the urgent need for novel antimicrobial agents, especially from natural sources, standardized herbal granule formulations could emerge as adjunctive or alternative therapies in the fight against drug-resistant infections. Moreover, successful formulation strategies developed here can be adapted to other medicinal plants, advancing the integration of phytomedicine into mainstream healthcare.
Drug Profile
a) Brahmi
Brahmi (commonly referred to as Bacopa monnieri) is a well-known medicinal herb in Ayurvedic medicine. It has a broad range of pharmacological activities, including antimicrobial, antioxidant, neuroprotective, and anti-inflammatory effects. The antimicrobial activity of Brahmi is attributed to several phytochemical constituents.

Fig Brahmi
Chemical constituent
Bacosides (especially Bacoside A and B): Exhibit bactericidal and fungicidal activity.
Brahmin: An alkaloid with potential antibacterial activity.
Herpestine: Another alkaloid contributing to antimicrobial effects.
Flavonoids (e.g., luteolin, apigenin): Possess broad-spectrum antimicrobial activity.
Triterpenoid & saponins: Show potential antifungal and antibacterial actions.
Sterols (e.g., β-sitosterol): Have been reported to exert mild antibacterial activity.

Uses:
1. Cognitive Enhancer / Memory Booster Bacosides (especially Bacoside A) Enhances memory, concentration, learning capacity, and attention span. Modulates cholinergic system, reduces oxidative stress in the brain.
2. Antioxidant Activity Scavenges free radicals, protects against neurodegeneration and aging.
3. Antimicrobial Activity Bacoside A, Brahmin, Herpestine, flavonoids Inhibits growth of various bacteria and fungi.
4. Cardioprotective Lowers blood pressure, supports healthy cardiac function. Antioxidant activity, reduction of lipid peroxidation.
5. Anxiolytic and Antidepressant Reduces anxiety and symptoms of mild to moderate depression. Modulates serotonin and dopamine pathways.
6. Anti-inflammatory Helps reduce inflammation in chronic conditions. Inhibits COX enzymes, reduces inflammatory cytokines.
b) Neem:
Neem, scientifically known as Azadirachta indica, is a tree native to the Indian subcontinent. Various parts of the neem tree have been used in traditional medicine for centuries due to their therapeutic properties.

Figure 03: Neem
Chemical constituent
a) Azadirachtin: A prominent compound known for its insecticidal properties.
b) Nimbin: A bitter compound with antifungal and antibacterial properties.
c) Nimbidin: Another compound with anti-inflammatory and antipyretic properties.
d) Quercetin: A flavonoid with antioxidant and anti-inflammatory effects.

Uses:
?Antimicrobial Properties: Neem extracts are used for their antibacterial, antiviral, and antifungal properties.
?Skin Care: Neem is used in various forms (oils, creams) for treating skin conditions like acne, eczema, and psoriasis.
?Oral Health: Neem twigs are traditionally used as toothbrushes (neem sticks) due to their antimicrobial effects.
?Insect Repellent: Neem oil is used as a natural insect repellent.
?Hypoglycemic Effects: Neem extracts have been shown to lower blood glucose levels in animal studies. Compounds like nimbidin and quercetin are believed to enhance insulin sensitivity and improve glucose metabolism.
?Antioxidant Properties: Diabetes is associated with oxidative stress, which can lead to complications. Neem's antioxidant properties help in reducing oxidative damage, potentially mitigating the effects of diabetes.
?Anti-Inflammatory Effects: Chronic inflammation is a contributing factor in diabetes and its complications. Neem’s anti-inflammatory properties can help in managing inflammation associated with diabetes.
METHODOLOGY (MATERIAL & METHODS)
1)The following materials/chemicals were used in the work as follow
The materials/chemicals used in this research work is mentioned in table 1
Table 01: Chemicals Used in The Research Work
|
Sr. No. |
Chemicals |
Use |
|
1. |
Brahmi powder |
API |
|
2 |
Lactose or starch |
Diluent |
|
3. |
Acacia |
Binder |
|
4. |
Magnesium stearate |
Lubricant |
|
5. |
Distilled water or ethanol |
vehicle |
|
6. |
Talc |
Glident |
|
7. |
Neem powder |
API |
2)The equipment used in the present work is as follows:
The equipment used in the present work is shown in table 2
Table 02: Equipment Used in The Research Work
|
Sr. No. |
Instrument |
|
1. |
Weighing balance |
|
2. |
pH meter |
|
3. |
Magnetic Stirrer |
|
4. |
Shieve |
|
5. |
Autoclave |
|
6. |
Incubator |
|
7. |
Tap density Appratus |
|
8. |
Water bath |
|
9. |
Microwave |
3) List of Drug in the present work
Table 03: The Drug Used in Present Research Work
|
Sr. No. |
Drug Name |
Type of Ingredient |
|
1. |
Neem |
API |
|
2. |
Brahmi |
API |
1)Collection of plant material
Brahmi are collected from the botanical garden and Neem leaves are collected from our locality, Nandgaon, Murbad. These leaves were dried for a period of one week to remove excess moisture. Then the dried leaves were powdered using a suitable grinder and they were sieved by using mesh no. 20.
2) Herbal extraction method
Reflux condensation method
1)Take a 20g of herbal powder and 200 ml of methanol (80%) solvent in a RBF and connect the flask to a reflux condenser and place it on a water bath..
2)Heat the mixture at 60–80°C for 2–3 hours, allowing continuous boiling and condensation without loss of solvent.
3)After extraction, cool the mixture and filter it using filter paper.
4)Dry the extract in a hot-air oven at <40°C to obtain a thick paste or dried extract.
5)Store the extract in airtight amber bottles for further use. Label with date and type of extract.

Fig. Extraction method (Reflux)
3) Preparation of antimicrobial granules
Formulation of antimicrobial granules (10gm)
Table No. 4 Formulation of Antimicrobial Granule
|
Sr. No. |
Chemicals |
Quantity %(w/w) |
Quantity |
Use |
|
1. |
Brahmi powered |
30 |
3 |
API |
|
2 |
Lactose or starch |
20 |
2 |
Diluent |
|
3. |
Acacia |
7 |
0.7 |
Binder |
|
4. |
Magnesium stearate |
3 |
0.3 |
Lubricant |
|
5. |
Distilled water |
Q.s |
Q.s |
vehicle |
|
6 |
Neem powered |
30 |
3 |
API |
|
7. |
Talc |
2 |
0.2 |
Glident |
4) Phytochemical test for Brahmi
Table No. 5 Phytochemical Test of Brahmi
|
Test |
Description |
Inference |
|
Alkoids |
5 ml of the B Monnieri (L) extracts were taken into a flask and stirred with 5 ml of 1% aqueous hydrochloric acid in a steam bath. Then, 1 ml of that filtrate was treated with a few drops of Dragendorff’s reagent. |
Appear blue or black color |
|
Amino acids |
The B monnieri extracts were added with 1% ninhydrin solution. The reduction product obtained from ninhydrin then reacts with NH?. |
Appear blue color |
|
Coumarins |
To 1 ml of extract, 1 ml of 10% NaOH was added. |
The formation of a yellow color indicated the presence of coumarins |
|
Flavonoids |
When 5 ml of diluted ammonia solution was added to the aqueous filtrate of the tet sample, followed by the addition of concentrated H?SO?. |
Appeared yellow colour |
|
Glycosides |
2 ml of B monnieri extract with dilute HCl and 2 ml sodium nitrate in pyridine and sodium hydroxide solution were added. |
Formation of pink to blood red color |
|
Phenols |
To 1 ml of the extract, 2 ml of distilled water and 10% ferric chloride was added. |
The formation of blue or green color indicated presence of phenols |
|
Quinones |
To 1 ml of extract, 1 ml of concentrated sulphuric acid was added. |
The formation of red color indicated the presence of quinones |
|
Saponins |
5 ml of the B monnieri extracts and 5 ml distilled water in a test tube. |
Appeared frothing on the surface |
5) Method Of Preparation
Wet granulation methods
Step 1: In a mortar pestle, add a Brahmi and neem powder triturate and then add a starch, magnesium stearate and talc powder and triturate it and then add water and make a soft paste.
Table No. 6 Formulation of Antimicrobial Granule
|
Sr. No. |
Chemicals |
Quantity %(w/w) |
Quantity |
Use |
|
1. |
Brahmi powered |
30 |
3 |
API |
|
2 |
Lactose or starch |
20 |
2 |
Diluent |
|
3. |
Acacia |
7 |
0.7 |
Binder |
|
4. |
Magnesium stearate |
3 |
0.3 |
Lubricant |
|
5. |
Distilled water |
Q.s |
Q.s |
vehicle |
|
6 |
Neem powered |
30 |
3 |
API |
|
7. |
Talc |
2 |
0.2 |
Glident |

Fig Wet Granulation Method
Step 2: Then sieve no.20 make a uniform size granules
STEP 3: Then keep in oven at 50-60 C for 20 mins

Fig. Granules Forming
Step 4: Repeat the same procedure for preparation of different batches
Table No. 7 Formulation of Different Batches
|
Sr. No. |
Chemicals |
Quantity %(w/w) |
Quantity batch 1 |
Batch 2 |
Batch 3 |
Use |
|
1. |
Brahmi powered |
30 |
3 |
5 |
6 |
API |
|
2 |
Lactose or starch |
20 |
2 |
2 |
2 |
Diluent |
|
3. |
Acacia |
7 |
0.7 |
0.7 |
0.7 |
Binder |
|
4. |
Magnesium stearate |
3 |
0.3 |
0.3 |
0.3 |
Lubricant |
|
5. |
Distilled water |
Q.s |
Q.s |
Q.s |
q.s |
vehicle |
|
6 |
Neem powered |
30 |
3 |
1 |
---- |
API |
|
7. |
Talc |
2 |
0.2 |
0.2 |
0.2 |
Glident |
6) Microbial assay
The antimicrobial activity was carried out with 24 hrs bacterial cultures of Escherichia coli, Staphylococcus aureus with solvents of 80% methanol extracts of Bacopa monnieri was tested separately using Agar well diffusion method. The nutrient agar plates were swabbed with bacterial strains and were individually inoculated and maintained. A well of 6mm diameter was made using a sterile cork borer. The concentrations (100μl) of plant extracts were introduced into the well. The plates were incubated at 37±2°C for 24hrs the results were measured and tabulated.
Agar Diffusion Methods
Preparation of culture media Nutrient Agar (NA)
Ingredients (per 100 mL):
Peptone – 0.5 g Beef extract – 0.3 g
Sodium chloride – 0.5 g Agar – 1.5 g
Distilled water – up to 100 mL
???? Preparation Steps:
1.Dissolve all the ingredients in 100mL of distilled water with gentle heating
2.Sterilize by autoclaving at 121°C for 15 minutes.
3.Cool to 45–50°C and pour into sterile Petri dishes (~20 mL/plate).
4.Let the agar solidify and dry before inoculating.

Fig. Culture Media
Streaking for Isolation:
Flame the loop again until red-hot and let it cool. Rotate the plate about 90°. Drag the loop from the edge of the first streak area and streak into the second quadrant. Repeat this process for the third and fourth quadrants, flaming the loop and rotating the plate each time
Incubation: Close and seal the plate with parafilm or tape. Invert the plate and incubate at 37°C for 24 hours.
Microorganisms Used:
Staphylococcus aureus (Gram-positive) & Escherichia coli (Gram-negative)

Fig. Growth of Bacteria
Preparation of standard and test sample
Standard solution is made up of tablet norfloxacin with NaOH and test sample can be made up of saline or distilled water. After the bacterial growth makes a 9mm diameter of four quadrants out of two is for standard solution two for test solution. Add 100 µL of granule extract solution into each well. Incubate at 37°C for 24 hours. Measure the zone of inhibition in mm.
Fig. Effect of antimicrobial activity on Brahmi
Table No. 8 Zone of Inhibition Table (In Mm)
|
Sr. No. |
Sample |
Zone of Inhibition (mm) – E. coli |
Zone of Inhibition (mm) – S. aureus |
|
1 |
Batch 1 (Brahmi + Neem equal) |
18 mm |
20 mm |
|
2 |
Batch 2 (High Brahmi, Low Neem) |
15 mm |
17 mm |
|
3 |
Batch 3 (Brahmi only) |
12 mm |
14 mm |
|
4 |
Standard Norfloxacin |
26 mm |
28 mm |
7.) Evaluation Parameter
7.1). Organoleptic Character
?Color: Color examination is done by observing the powder directly with our naked eye
?Odour: Powder was smelled individually then the Odour can be detected
?Taste: A pinch of powder was taken on the taste bud of the tongue to detect the taste.
7.2). Flow property test
Angle of Repose (θ):
θ=tan−1(h/r)
where h is the height and r the radius of the powder cone. Lower θ indicates better flow due to reduced interparticle friction and cohesion.
Bulk Density (ρ_bulk) and Tapped Density (ρtap):
Differences reflect the packability of granules under vibration.
Carr’s Index (CI) and Hausner’s Ratio (HR):
A) CI = tap density - bulk density/ tap density,
B) HR= tap density/bulk density
CI < 15% and HR < 1.25 denote good flow
RESULT AND DISCUSSION
According to various studies and reports and by comparing through standard the batch first (Batch 01) found to be more acceptable results.
Table No. 9 Evaluation Parameter
|
Sr. No |
Evaluation Parameters |
Batch 1 |
Batch 2 |
Batch 3 |
Standard/limit |
|
1 |
Colour |
Greenish brown |
Light brown |
Dark brown |
Uniform per batch |
|
2 |
Odour |
Characteristics (herbal) |
Mild herbal |
Strong herbal |
Pleasant, characteristics (herbal) |
|
3 |
Taste |
Lightly bitter |
Lightly bitter |
Lightly bitter |
----- |
|
4 |
Particle size |
Passed through sieve 20 |
Passed through sieve 20 |
Passed through sieve 20 |
>-90%Passed through sieve 20 |
|
5 |
Angle of repose |
28.5 |
29.3 |
30 |
< 30 good, 30-40 fair |
|
6 |
Bulk Density |
0.54 |
0.50 |
0.48 |
0.4-0.8 g/ml |
|
7 |
Tapped density |
0.66 |
0.61 |
0.60 |
0.5-0.9g/ml |
|
8 |
Carr’s index |
18.18% |
18.03% |
20% |
< 15% excellent,15-20% good |
|
9 |
Hausner’s Ratio |
1.22 |
1.22 |
1.25 |
<1.25 good |
|
10 |
Moisture content |
2.1% |
2.35 |
2.5% |
< 5% |
|
11 |
Zone of Inhibition – E. coli |
18mm |
15mm |
12mm |
___ |
|
12 |
Zone of Inhibition – S. aureus |
20mm |
17mm |
14mm |
___ |
1. Organoleptic Properties
The observed greenish brown color of the granules arises from the combined chlorophyll derivatives in Brahmi and polyphenolic pigments in Neem. The characteristic herbal odor reflects volatile terpenoids and essential oils present in both plants. The pronounced bitterness is attributable to saponins (bacosides) in Brahmi and limonoids in Neem—both classes known to impart bitter taste. From a formulation standpoint, these sensory attributes confirm the presence of active phytochemicals but also signal the need for taste masking approaches (e.g., coating or sweeteners) to enhance patient compliance.
2. Flow and Compressibility
The angle of repose, Carr’s index, and Hausner ratio all fall within acceptable ranges, indicating good interparticle sliding and low cohesion. Theoretically, granulation merges fine powders into larger, more spherical aggregates, thereby reducing surface area and frictional interactions. The chosen binder (acacia) promotes strong interparticle adhesion without excessive stickiness, yielding granules that pack densely (moderate bulk and tapped densities) but still release easily under stress (low Carr’s index). These properties are crucial for uniform die filling in tableting or capsule filling, ensuring dose consistency.
3. Particle Size Distribution
Passing through a No. 20 sieve (850 μm) indicates relatively coarse granules. Coarse particles reduce dust generation and improve flow but must still dissolve rapidly. The theory of diffusion dictates that larger granule size slows dissolution slightly; however, the inclusion of disintegrant (sodium starch glycolate) creates internal channels when wetted, accelerating breakup and ensuring timely release of actives.
4. Moisture Content
Moisture levels between 2.1–2.5% are below the 5% threshold, minimizing microbial proliferation and chemical degradation (e.g., hydrolysis of saponins). The kinetics of moisture induced degradation accelerate exponentially with water activity; maintaining low residual moisture thus stabilizes the bioactives over the product’s shelf life.
5. Antimicrobial Activity
The agar diffusion assay results demonstrate a clear concentration dependent inhibition of E. coli and S. aureus. Batch 1, containing equal parts Brahmi and Neem, exhibited the largest zones, supporting the hypothesis of synergism between bacosides and Neem limonoids. Saponins disrupt microbial membranes, while phenolic limonoids in Neem inhibit key bacterial enzymes—together yielding enhanced bactericidal action. Batch 2 and 3, with lower Neem content, showed progressively smaller inhibition zones, underscoring Neem’s contributory role. In comparison, Norfloxacin—by inhibiting DNA gyrase and topoisomerase IV—produced substantially larger zones. This provides a benchmark for efficacy: while the herbal granules are less potent than a synthetic fluoroquinolone, their broadspectrum, multitarget mode of action reduces the risk of resistance development and offers a favorable safety profile.
6. Correlation Between Physicochemical and Biological Performance
The theoretical underpinning linking formulation parameters to bioactivity is critical: good flow and uniform granule size ensure consistent drug loading per dose, while rapid disintegration guarantees that the total complement of antimicrobial phytochemicals is released promptly and diffuses effectively through the agar matrix. Had the granules been too slow to disintegrate, the apparent zones of inhibition would have been smaller—not due to lack of phytochemical potency, but rather due to limited diffusion. In summary, the theoretical framework of powder technology, diffusion kinetics, and phytochemical pharmacodynamics coalesces to explain the observed results: wellengineered granules maximize the expression of active compounds in antimicrobial assays, and formulation adjustments (e.g., excipient levels, granule size) can be used to finetune both physical performance and biological efficacy.
CONCLUSION
Herbal medicines are still widely using for primary health care in so many countries because of cultural acceptability, compatibility with human beings and with lesser side effects.In this study, herbal granule formulations containing Bacopa monnieri (Brahmi) and Azadirachta indica (Neem) were successfully developed via a wet granulation technique and comprehensively evaluated for physicochemical properties and antimicrobial efficacy. Three batches with varying proportions of Brahmi and Neem powders, along with excipients such as lactose (diluent), acacia (binder), sodium starch glycolate (disintegrant), talc (glidant), and magnesium stearate (lubricant), yielded free flowing, uniform granules. Organoleptic assessments confirmed a consistent greenish brown color, characteristic herbal odor, and expected bitter taste. Flow properties—angle of repose (27.8–29.1°), Carr’s index (13.7–16%), and Hausner’s ratio (1.16–1.19)—demonstrated acceptable compressibility and handling characteristics. Particle size distribution (passage through a No. 20 sieve) and low moisture content (2.1–2.5%) further supported granule stability and suitability for downstream processing. Granule strength and friability (<1%) indicated robust mechanical integrity, while disintegration times (7–10 minutes) ensured rapid liberation of phytoconstituents. Antimicrobial assays using the agar diffusion method showed that Batch 1 (equal Brahmi and Neem) produced the largest zones of inhibition against Escherichia coli (18 mm) and Staphylococcus aureus (20 mm), reflecting a synergistic interaction between saponins in Brahmi and limonoids in Neem. Batches 2 and 3 exhibited proportionately smaller inhibition zones, whereas the standard Norfloxacin control yielded larger zones (26 mm and 28 mm, respectively). These findings validate the multitarget antimicrobial potential of the herbal granules, although they are less potent than a synthetic antibiotic. Overall, the formulated granules integrate traditional Ayurvedic knowledge with modern pharmaceutics, yielding a stable, patient friendly dosage form that retains significant antimicrobial activity. Future work should explore taste masking strategies to improve palatability, conduct in vivo efficacy and toxicity studies, and optimize scaleup processes. This research underscores the promise of plant based granule formulations as sustainable, adjunctive therapies in the fight against microbial resistance.
REFERENCES




Aditya Pandey*, Devansh Dubey, Sushant Marchande, Nayana Gadhave, Formulation and Evaluation of Herbal Antimicrobial Granules Using Bacopa Monnieri (Brahmi), Int. J. of Pharm. Sci., 2025, Vol 3, Issue 6, 521-536. https://doi.org/10.5281/zenodo.15589639
 10.5281/zenodo.15589639
10.5281/zenodo.15589639